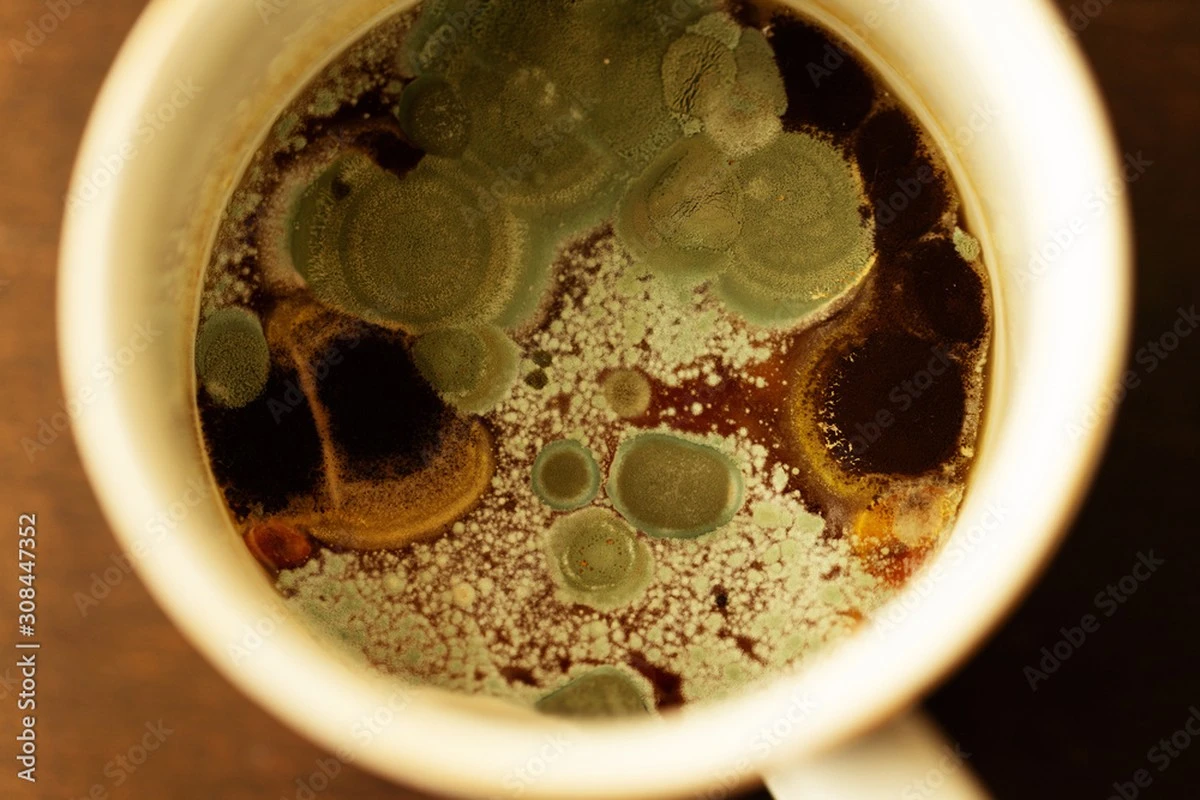
dlaczegodoswiad-extra-1.webp Dlaczego doświadczeni technolodzy żywności nigdy nie piją herbaty z wczoraj - image 1

Przez lata robiłem to samo: rano dopijałem herbatę, którą zaparzyłem wieczorem, albo po prostu ją podgrzewałem. Wydawało mi się to oszczędne i wygodne, dopóki moja mama, która od lat pracuje w przemyśle spożywczym, nie zadała mi jednego pytania: "Czy ty wiesz, co zdążyło tam urosnąć przez noc?".
To, co usłyszałem, całkowicie zmieniło moje poranne nawyki. Okazuje się, że to, co bierzemy za "zwykły osad" na ściankach naczynia, jest w rzeczywistości sygnałem ostrzegawczym, którego nie wolno ignorować, jeśli dbamy o swój żołądek i wątrobę.
Ciemny osad to nie tylko barwnik
Zauważyliście kiedyś tę cienką, połyskującą warstwę na powierzchni herbaty, która stała kilka godzin? W Polsce często kładziemy to na karb "twardej wody", ale prawda jest bardziej złożona. To wynik utleniania związków organicznych.
Kiedy herbata stoi w temperaturze pokojowej, zachodzą w niej procesy chemiczne:
- Cenne antyoksydanty ulegają rozpadowi.
- Minerały łączą się z tlenem, tworząc ciężkostrawne związki.
- Herbata staje się idealną pożywką dla drobnoustrojów.
"Przecież ją podgrzewam" – dlaczego to nie działa?
Też tak myślałem. Wstaję, wrzucam kubek do mikrofalówki albo dolewam wrzątku i gotowe. Jednak, jak wyjaśniła mi mama, podgrzewanie nie usuwa toksyn produkowanych przez bakterie. Niektóre z nich są termostabilne.
Wyobraźcie sobie pokój, w którym były myszy. Możecie wygonić gryzonie, ale ich odchody zostają. Dokładnie tak samo jest z wczorajszą herbatą – zabijesz bakterie wysoką temperaturą, ale szkodliwe produkty ich metabolizmu nadal tam są i czekają, aż je wypijesz.
Co dzieje się z herbatą po 24 godzinach?
W laboratorium sprawa wygląda jasno. Poziom azotynów drastycznie rośnie, a wilgotne środowisko liści to raj dla pleśni, która nie zawsze jest widoczna gołym okiem. Picie takiego naparu regularnie to ogromne obciążenie dla Twojej wątroby, która musi filtrować te wszystkie "odpady".
Nowy rytuał: Zasady świeżego naparu
Przejście na świeżą herbatę zajęło mi tydzień, ale różnica w samopoczuciu (i smaku!) jest kolosalna. Oto zasady, których teraz trzymam się w swojej kuchni:
- Zasada 15 minut: Herbatę najlepiej wypić w ciągu kwadransa od zaparzenia.
- Usuwaj liście: Nigdy nie zostawiaj torebki ani liści w kubku na dłużej niż 4 minuty. Po tym czasie uwalnia się zbyt dużo garbników, które psują smak i obciążają żołądek.
- Myj, nie płucz: Osad z herbaty to doskonałe miejsce do rozwoju bakterii, dlatego filiżankę trzeba myć dokładnie po każdym użyciu.
Herbatę traktujemy jak napój, który może stać wiecznie, jak woda w butelce. Ale herbata to produkt "żywy", który zmienia się z każdą minutą. Dzisiaj wolę poświęcić te dodatkowe trzy minuty rano na zaparzenie świeżego kubka, niż fundować swoim organom chemiczny koktajl z wczoraj.
A Wy jak często zostawiacie niedopitą herbatę "na później"? Mieliście pojęcie, że ten niewinny nawyk może mieć takie skutki?









